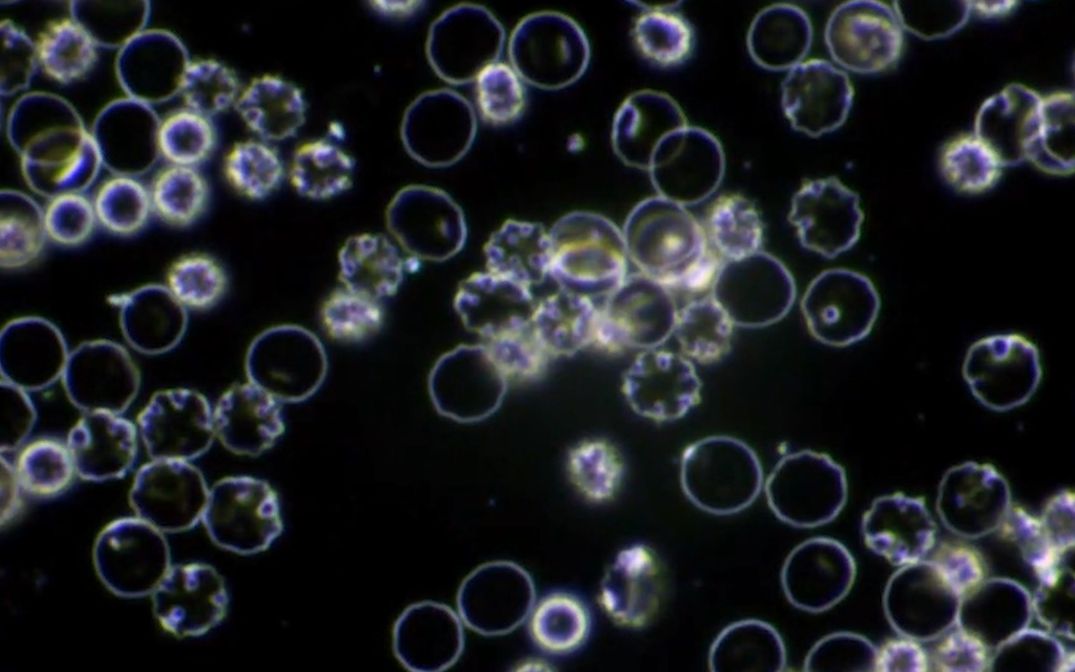
带你看工作细胞显微镜观察血细胞含暗场

暗场

直观测试 暗场和色阶表现并不如之前那么差
图片尺寸500x333
带你看工作细胞显微镜观察血细胞含暗场
图片尺寸1075x672
明场照明和暗场照明怎么选
图片尺寸591x410
5 明场照明和暗场照明
图片尺寸719x439
主题:我们拍的明场像和暗场像为什么区别不大?
图片尺寸340x341
萨伽配件光学生物显微镜专业级干式暗场装置聚光镜暗视野观察标本
图片尺寸800x800
有趣的材料科学——什么叫明场像,什么叫暗场像?
图片尺寸640x197
暗场散射显微法原理图 figure schematic diagram
图片尺寸1476x943
bfvdf 明场v暗场翻译_第2页
图片尺寸920x1302
什么是暗场显微观察? | 奥林巴斯生物显微镜
图片尺寸460x300
转明场像与暗场像都有什么区别呢
图片尺寸618x280
奥林巴斯显微镜暗场显微镜的照明
图片尺寸400x256
明场与暗场照明在机器视觉中的应用 苏州灵猴机器人有限公司_直线电机
图片尺寸911x937
100x奥林巴斯暗场
图片尺寸2000x1333
图4 不含ce及含0.11% ce合金t8峰时效时的saed谱及tem暗场像
图片尺寸600x620
明场照明和暗场照明的区别
图片尺寸869x378
光影流转 星空璀璨的景象90灰蓝的色系在暗场灯光的映射下ji具未
图片尺寸1080x1439
明场和暗场照明
图片尺寸422x298
暗场散射光谱丨小尺度结构研究必备
图片尺寸550x456
暗场逆光打在水晶上像teamlab展
图片尺寸1080x1080